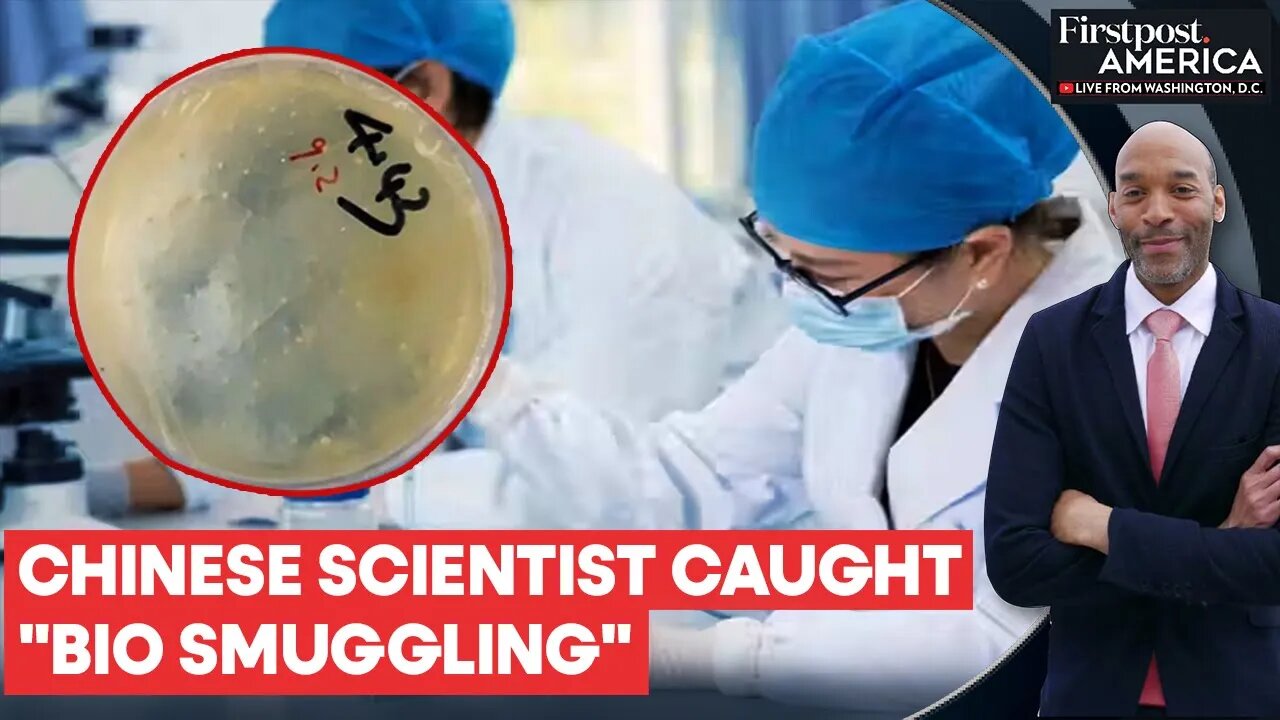

Premium Only Content
Another Chinese Scientist Arrested in US Over Biotech Smuggling _ Firstpost America _ N18G
Another Chinese Scientist Arrested in US Over Biotech Smuggling | Firstpost America | N18G
US authorities have arrested Chengxuan Han, a Chinese scientist, for allegedly smuggling biological materials into the country without proper permits. She was taken into custody at Detroit Metropolitan Airport after arriving from Shanghai. According to federal documents, Han had previously mailed biological samples described by the FBI as involving worms to staff at the University of Michigan, where she intended to conduct research. She now faces charges of smuggling goods and making false statements. Han, a postgraduate student at Huazhong University of Science and Technology in Wuhan, was planning to spend a year in Michigan. This is the second recent case involving suspected unauthorized transport of sensitive scientific material from China to the US.
----
Chengxuan Han | Chinese scientist | Detroit Metropolitan Airport | FBI | University of Michigan | Huazhong University | China | United States | Firstpost America | Eric Ham | War | Geopolitics | Global Economy | Firstpost | World News | Latest News | Global News | International News | Trending News
#chengxuanhan #chinesescientist #detroitairport #fbi #universityofmichigan #huazhonguniversity #china #usa #firstpostamerica #ericham #war #geopolitics #economy #firstpost #worldnews #latestnews #globalnews #internationalnews #trendingnews
Firstpost is an Indian news and media website. Get all the incisive opinions, in-depth analyses and other visual stories that matter to you and the world right here on this channel.
Subscribe to Firstpost channel and press the bell icon to get notified when we go live.
https://www.youtube.com/@Firstpost
Follow Firstpost on Instagram:
https://www.instagram.com/firstpost/
Follow Firstpost on Facebook:
https://www.facebook.com/firstpostin/
Follow Firstpost on Twitter:
https://twitter.com/firstpost
Follow Firstpost on WhatsApp:
https://www.whatsapp.com/channel/0029Va6zOIrEQIamseyg762V
-
 5:45
5:45
Firstpost
11 hours agoLadakh Unrest: Sonam Wangchuk Detained, Curfew Imposed | Vantage with Palki Sharma
10 -
 LIVE
LIVE
Lofi Girl
2 years agoSynthwave Radio 🌌 - beats to chill/game to
322 watching -
 4:23:47
4:23:47
MissesMaam
8 hours ago*Spicy* Friend Friday with Mally_Mouse and Friends!! 💚✨
291K16 -
 2:05:09
2:05:09
TimcastIRL
9 hours agoRIOTS Leftist ATTACK ICE, Tear Gas Deployed, Feds Ordered To IGNORE CA Law, CIVIL WAR! | Timcast IRL
323K236 -
 15:57
15:57
Robbi On The Record
1 day ago $8.59 earnedTranshumanism: Are Humans Becoming Obsolete? Neuralink & CRISPR explained
47.2K20 -
 2:22:21
2:22:21
TheSaltyCracker
9 hours agoICE Smashing Antifa ReeEEStream 9-26-25
121K181 -
 7:47:28
7:47:28
SpartakusLIVE
10 hours ago#1 HERO of the PEOPLE || Ending the Week with FUN, WINS, and LAUGHS
85.7K -
 3:52:22
3:52:22
SynthTrax & DJ Cheezus Livestreams
20 hours agoFriday Night Synthwave 80s 90s Electronica and more DJ MIX Livestream THE FLOATING WORLD / Variety Music Edition
41.6K3 -
 7:43:24
7:43:24
Eternal_Spartan
16 hours ago🟢 Eternal Spartan Plays Destiny 2 | FPS Friday | | USMC Veteran
49.8K4 -
 2:04:11
2:04:11
MattMorseTV
10 hours ago $23.04 earned🔴The UK just hit ROCK BOTTOM.🔴
78K182